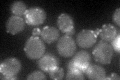
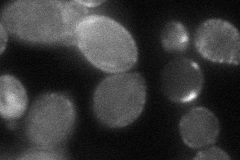
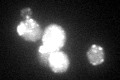
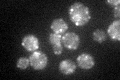

View description
One of two type I myosins; localizes to actin cortical patches; deletion of MYO3 has little effect on growth, but myo3 myo5 double deletion causes severe defects in growth and actin cytoskeleton organization
Localization:
Intensity:
Fold change:
Significance:
-
C’ GFP library in SD
punctate:cytosol41.34 -
N' NOP1pr-GFP in SD

cell periphery,ER93.988 -
N' TEF2pr-mCherry in SD

cell periphery,punctate128.669 -
N' NATIVEpr-GFP in SD

punctate26.2829 -
N' TEF2pr-VC and Cyto-VN in SD
cell periphery,punctate50.8935 -
C’ GFP library in SD+DTT
punctate.cytosol69.081.67Yes -
C’ GFP library in SD+H2O2

punctate.cytosol48.131.16No -
C’ GFP library in Starvation Media
punctate,cytosol60.591.46Yes -
C’ GFP library on the background of Pup2-DaMP

punctate:cytosol -
C’ GFP library on the background of CCT mutant

punctate:cytosol47.68491.15322No
